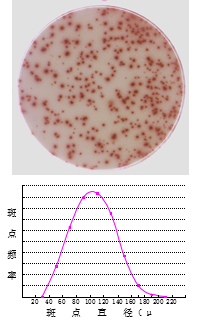

您好,歡迎光臨達科為生物城!
免費熱線電話 : 400 819 7199 (工作日:8:30 - 17:30)
收藏達科為生物城

ELISPOT斑點的特征
“一個陽性細胞,對應一個ELISPOT斑點”,這是ELISPOT檢測的理論前提。無數的實驗也證明了這一點。現有的抗體技術以及酶聯放大技術確實可以把單個細胞分泌細胞因子的行為記錄下來,ELISPOT板上的每一個斑點就是好的證明。下面我們來看一看ELISPOT斑點的特征。
圓形,有暈核結構

這是判定真假ELISPOT斑點的主要標準。ELISPOT斑點有
這種結構可以從幾何學的原理得到很好的理解和解釋(如圖
1.2所示)。懸浮在ELISPOT板膜上的細胞,它分泌細胞因子
是沒有方向性的,均勻地向四面八方擴散,如果擴散到
ELISPOT板膜,就會被板膜上的包被抗體捕獲。在所有從細胞到斑膜的路徑中,有條路徑短,這就是位于細胞正下方到板膜的垂直距離。路徑越短,擴散中耗散損失就越少,到達該點的細胞因子就越多,將來顯色的時候顏色就越深。以垂直距離點為圓心,向外畫一系列的同心圓,同心圓的直徑越大,細胞因子擴散的距離就越長,耗散越多,到達的細胞因子就越少,顏色就越淺。當超過一定距離之后,擴散到達的細胞因子就減少到背景水平了,這就是斑點的邊界。
大小不均一,正態分布
ELISPOT斑點要比產生它的那個細胞大很多。我們知道,
哺乳動物細胞的直徑約是5-10μm,而ELISPOT斑點的直徑通常是50-150μm,比細胞大10倍以上。
同一類陽性細胞,受到相同的刺激,產生的斑點大小也不完全相同。這些斑點大小不一,但是如果把它們的直徑統計出來,這發現它們呈正態分布的,見圖1.3。
需要說明的是,不同的細胞,對不同的刺激物,不同的細胞因子,ELISPOT斑點的直徑(平均直徑)也不同。通常來說,T細胞產生的斑點較大,單核巨噬細胞產生的斑點小;特異性的抗原(多肽或者蛋白)刺激產生的斑點大,非特異性的有絲分裂原(PHA、ConA等)刺激產生的斑點小;IFN-γ、IL-4等細胞因子的斑點大,IL-10、IL-12、Granzyme B之類的細胞因子的斑點小。
如果一次實驗中有兩類細胞同時受到刺激,比如T細胞與巨噬細胞,或者一次實驗中T細胞受到兩種不同的刺激物刺激,比如蛋白抗原與內毒素(大腸桿菌表達的蛋白很可能含有較高濃度的內毒素),那么同一個孔中就會出現兩種不同的斑點。這兩種斑點用肉眼很難區別,但是如果對它們直徑分布做統計作圖的話,就會有別于圖1.3中的單峰分布,而是呈現雙峰分布。
© 2013 版權所有 北京達科為生物技術有限公司




